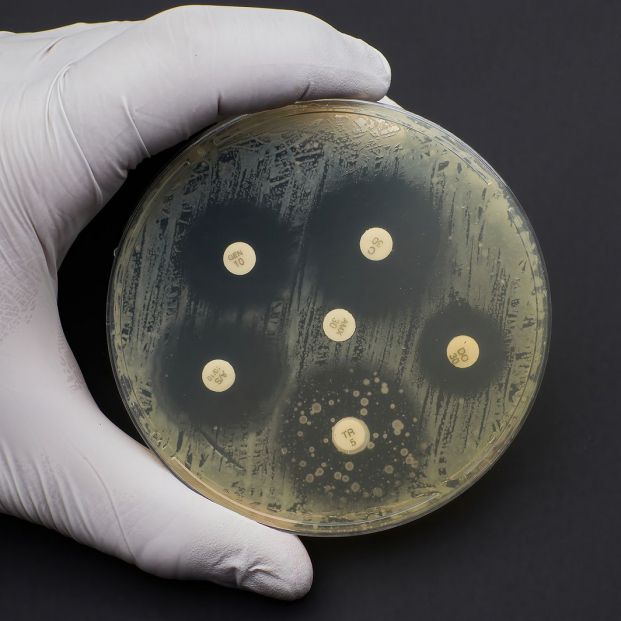
Resistencia a los antibióticos: al borde una auténtica crisis mundial

Resistencia a los antibióticos: al borde una auténtica crisis mundial
La semana pasada semana, una revista del prestigio de The Lancet avisaba de la próxima amenaza para la salud global que suponían las resistencias a los antibióticos. Las bacterias resistentes –dice– acaban con la vida de 1,2 millones de personas en el mundo cada año. Más que el sida, la malaria o el cáncer de pulmón .
La magnífica arma terapéutica que son los antibióticos pueden perder parte de su efectividad por la aparición de cepas resistentes. Solo un uso correcto podrá mantener su eficacia ante las infecciones. Pero no tomamos conciencia de ello. En muchas ocasiones, los consumimos para tratar procesos virales, contra los que nada pueden los antibióticos; o cesamos el tratamiento antes de tiempo, con lo que damos armas a las bacterias para que se protejan contra los antimicrobianos; o nos automedicamos con el resto de un tratamiento anterior contra un germen contra el que ese antibiótico tiene menos eficacia.
El botiquín casero es una fuente importante de automedicación. El dato es tan curioso como sorprendente: entre los medicamentos que se guardan en casa (entre 7 y 28 especialidades), hay casi en la mitad un antibiótico.Todo forma parte de la misma rueda. Al no cumplir el tratamiento, se guarda a medio uso; y se vuelve a emplear libremente en una nueva ocasión. No reparamos en que la interrupción del tratamiento altera la ecología de las bacterias, les da capacidad para desarrollar resistencias. Y no es una cuestión individual. La aparición de resistencias, o de nuevas cepas alteradas, es algo que afecta a toda la comunidad. Las resistencias bacterianas están poniendo a la antibioterapia al borde una auténtica crisis mundial.
Las causas
Partamos de la base de que los microorganismos –bacterias, hongos, parásitos y virus– son responsables de distintas enfermedades infecciosas y que los antimicrobianos han servido y sirven para contrarrestarlos y para evitar su propagación. Sin embargo, su empleo indiscriminado, para curar o para prevenir, con dosis o tiempo de empleo sin mucho control, fuerzan a esos microorganismo a adaptarse o a morir. Es lo que se llama presión selectiva. Los que sobreviven son portadores de los genes de resistencias. Y desde el plano médico eso quiere decir que un microorganismo resistente es un microorganismo que no puede ser vencido por un tratamiento clásico.
La propia Organización Mundial de la Salud llama la atención en este sentido. Especialmente, porque esos antimicrobianos se utilizan en agricultura, ganadería y piscicultura para tratar o controlar las infecciones o para activar el crecimiento y mejorar la rentabilidad. Esos usos incrementan la presión selectiva total que se ejerce sobre los agentes infecciosos y que, por tanto, aceleran la aparición de resistencias.
Propagación
No es complejo el mecanismo por el que se pueden propagar las resistencias. Inicialmente las bacterias resistentes pueden pasar fácilmente de una persona a otra, contagiándole la infección. El problema más serio es que precisamente por su rápida multiplicación, las bacterias pueden transferir los genes resistentes a otras cepas. Eso significa que en los centros sanitarios que utilizan antimicrobianos con profusión o en lugares donde se concentran enfermos infecciosos, la transmisión de bacterias resistentes es frecuente. Si además las condiciones sanitarias no son las adecuadas, la posibilidad de crecimiento de cepas alteradas es mayor.
La preocupación mundial surge cuando se evidencia que las bacterias también viajan. Y que aparecen en cualquier lugar del mundo cepas que adquieren resistencia en Asia o en África. Por si fuera poco , como ha ocurrido con la salmonela o la compylobactyer, puede pasar de los animales o a través de los alimentos al ser humano.
Otro problema añadido es que analizar la resistencia no es sencillo, porque exige una dedicación y unas instalaciones de las que no siempre se dispone. Así, no se conoce cuál es la sensibilidad ni qué antimicrobiano concreto podría ser efectivo.
Consecuencias
La primera consecuencia es el fracaso terapéutico y, por tanto, la prolongación de la enfermedad, con todo lo que lleva consigo. Puede también aumentar el número de enfermos y el tiempo de enfermedad.
Sin apelar a datos económicos, ya se comprueba que el gasto es mucho mayor. Pero es que al no ser efectivos los antimicrobianos iniciales, se deben utilizar otros más potentes, por otras vías o de mayor costo, algo que si ya es importante en nuestro entorno, puede ser definitivo para la salud pública de los países en desarrollo.

Tomar conciencia
Lo primero que debemos tener presente es que la resistencia es una respuesta natural de los microbios a los agentes antimicrobianos. Por eso, habría que abundar en campañas contra el uso excesivo e inapropiado de antimicrobianos.
Y, desde luego, evitar el abuso en usos veterinarios y agrícolas. Es verdad que a veces se les atribuye poderes de curación que no tienen y en ocasiones se toman antibióticos sin conocer la causa de la infección. Interrumpir el tratamiento prematuramente es lo que crea quizá el mejor entorno para que los agentes infecciosos puedan desarrollar las resistencias.
Medidas a tomar
La Sociedad Española de Quimioterapia, en un espléndido trabajo sobre automedicación y almacenamiento de antibióticos, propone un decálogo que todos deberíamos tener en cuenta:
- No todas las infecciones hay que tratarlas con antibióticos
- No utilice antibióticos sin prescripción médica
- Un antibiótico que ha resultado eficaz en un proceso determinado, puede no serlo en otro.
- Acuda a la consulta de su médico, ya que en base a un diagnóstico específico, el médico le prescribirá el antibiótico más adecuado en cada caso.
- Cumpla correctamente el tratamiento, siguiendo la pauta de administración establecida por el médico.
- No abandone el tratamiento hasta el día indicado por el médico. Aunque la fiebre desaparezca, la infección puede continuar.
- Si en el momento de adquirir la medicación no recuerda las instrucciones del médico, consulte con su farmacéutico.
- No almacene medicamentos ni los tire al cubo de la basura. Devuelva los envases con dosis sobrantes a su farmacia.
- El mal uso de los antibióticos crea resistencias bacterianas e hipoteca el tratamiento de otras personas.
- Sea solidario y utilice correctamente los antibióticos.